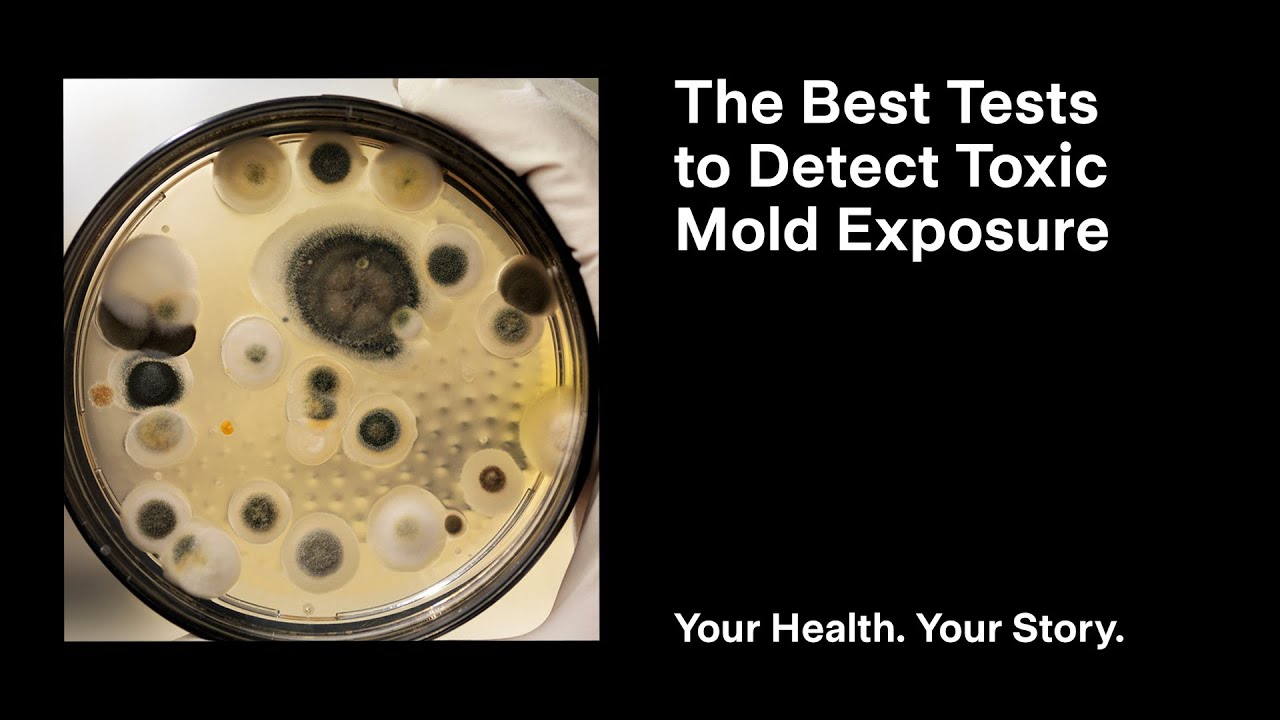
The Best Tests to Detect Toxic Mold Exposure - YouTube

How to Test for Mold Poisoning: Signs, Tests, and Steps to Take
Mold poisoning, often overlooked yet potentially serious, occurs when exposure to toxic mold spores triggers adverse health effects. Identifying mold-related illness starts with recognizing symptoms and taking proactive steps to test for mold in your environment. Understanding how to test for mold poisoning empowers you to protect your health and create a safer living space.

www.planetnaturopath.com
Recognizing Symptoms of Mold Poisoning
Mold poisoning symptoms vary widely but commonly include respiratory issues like coughing, wheezing, and sinus congestion, along with fatigue, headaches, skin rashes, and mood changes such as anxiety or depression. Severe exposure may lead to persistent infections or neurological effects. Since symptoms mimic other conditions, consulting a healthcare provider is essential for accurate diagnosis and targeted testing.

www.wikihow.com
At-Home Mold Testing Kits and Methods
Home mold testing kits offer a convenient first step to detect mold spores indoors. These kits usually include swabs, air monitors, or surface sampling tools. While useful for identifying visible mold or airborne particles, they may lack precision for comprehensive analysis. Proper collection and handling are critical—follow instructions carefully to avoid contamination and ensure reliable results before sending samples to certified labs.

www.pinterest.com
Professional Mold Testing and Health Evaluation
For definitive diagnosis, professional mold testing is recommended. Certified environmental inspectors use advanced equipment like air pumps, moisture meters, and lab-grade air sampling devices to measure mold levels and types. They often combine physical inspection with medical evaluation, analyzing symptoms in context of test results to confirm mold-related illness and guide treatment plans tailored to individual exposure.

dryeffect.com
Medical Assessment and Confirmatory Tests
A healthcare provider may order blood tests, urine analysis, or immunological assays to detect toxins like mycotoxins or triggered immune responses linked to mold exposure. These tests, combined with detailed medical history and symptom evaluation, confirm mold poisoning and help determine appropriate interventions, from antifungal therapies to environmental remediation.

equi.life
Testing for mold poisoning involves recognizing symptoms, using at-home kits for preliminary insights, engaging professionals for accurate assessment, and undergoing medical testing to confirm exposure. Early detection and proper diagnosis are key to mitigating health risks and restoring a safe, mold-free environment.
www.youtube.com

www.youtube.com

www.youtube.com